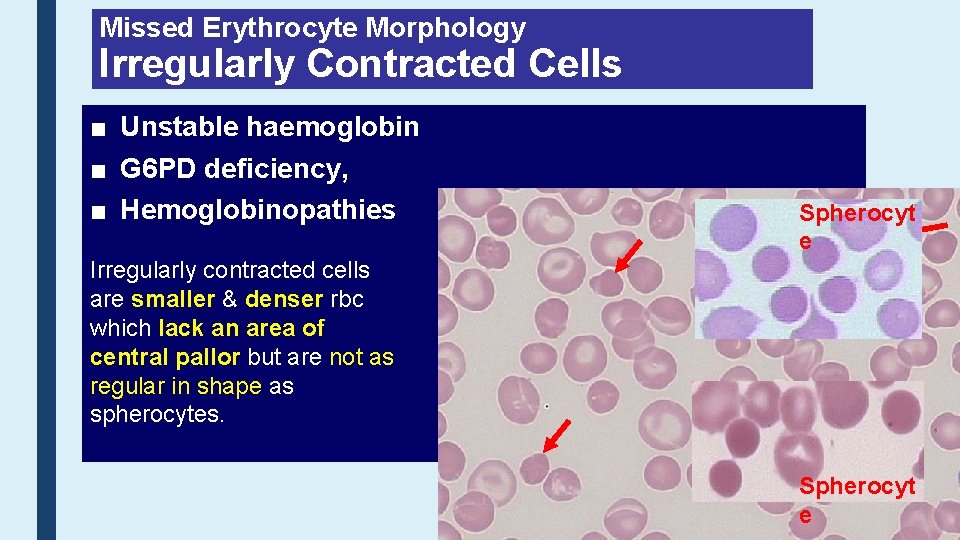
Missed Erythrocyte Morphology Irregularly Contracted Cells ■ Unstable haemoglobin ■ G 6 PD deficiency,
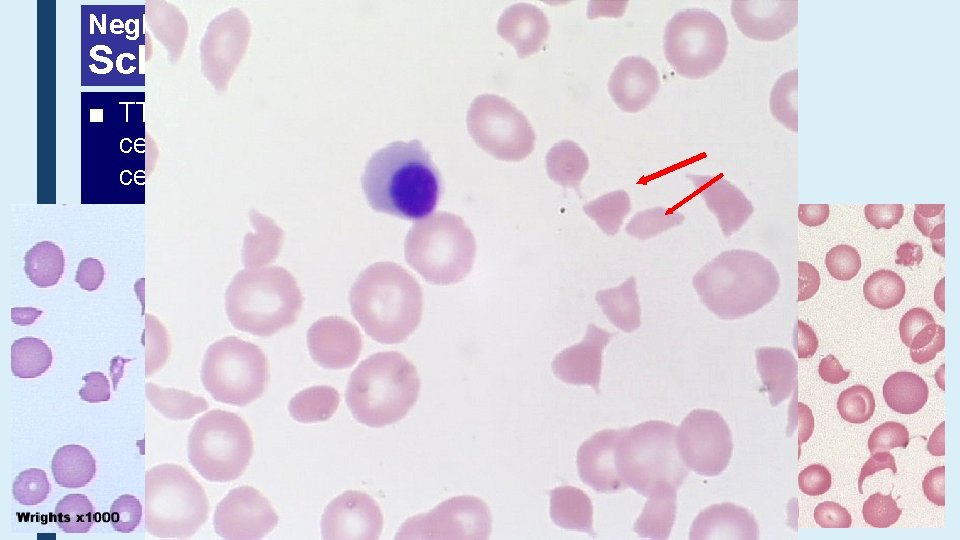
Neglected Erythrocyte Morphology Schistocytes ■ TTP, HUS, DIC – a wide range of fragmented

Payvand Clinical Specialty Lab Network Member of Molecular

Payvand Clinical Specialty Lab. Network Member of Molecular Diagnostic Centers of IFCC Challenges /New Parameters or Tests in the Laboratory Diagnosis of Anemia Dr. Behzad Poopak, DCLS Ph. D. Associate Professor of Hematology Islamic Azad University, Tehran Medical Branch With Quality Certificate Awarded By Health Reference Laboratory Ministry Of Health and Medical Education

Objectives I will review following topics in my presentation: ■ Erythrocyte Morphology Challenges ■ Reticulocyte parameters & its application in Anemia Diagnosis ■ Diagnostic Approach to Auto-Immune Hemolytic Anemia ■ PNH Diagnostic Problems

Erythrocyte Morphology Challenges ■ Different Nomenclature ■ No correlation bet. Morphology & Pathology or Interpretation ■ No common grading system ■ Some erythrocyte morphology missed ■ Different report format ■ Role of Automation in morphology assessment

2015 John Wiley & Sons Ltd, Int. Jnl. Lab. Hem. 2015, 37, 287– 303

Erythrocyte Morphology ICSH important recommendation ■ The use of grading some cell morphology using Cell Counter parameters ■ Higher level of accuracy & precision compared with observer use of the optical light microscope, ■ Example: rbc size abnormalities –MCV for microcytosis and macrocytosis, and MCH for hypochromia and hyperchromia. ■ However, it is important that the laboratory establishes policies to review peripheral blood smears

Morphology Grading Table ■ Grading is not equal for all morphology ■ Few/+ applied only for schistocyte
Missed Erythrocyte Morphology Irregularly Contracted Cells ■ Unstable haemoglobin ■ G 6 PD deficiency, ■ Hemoglobinopathies Spherocyt e Irregularly contracted cells are smaller & denser rbc which lack an area of central pallor but are not as regular in shape as spherocytes. Spherocyt e
Neglected Erythrocyte Morphology Schistocytes ■ TTP, HUS, DIC – a wide range of fragmented red cells with polychromatic cells and other damaged cells. Platelets are absent from the film

Helmet Cells

Typical Erythrograms Volume Cold Agglutinins: RBCs 4. 41 after 370 C Cell Hb

Cold Autoagglutination

Reticulocyte Count & its Parameters Pitfalls ■ Reticulocyte Definition? ■ Report format: % or Absolute count ■ Manual (CV: 20%) or automated Retic. Count? ■ Important Retic. Parameters: IRF (Immature Reticulocyte Fraction), CHr (mean hemoglobin content of reticulocytes) ■ Is Lab responsible for Reticulocyte production index (RPI) Hct of Patient 1 calculation? ■ RPI = Relative Retic. Count XHct of Normal SAMG, January 2017, Vol. 107, No. 1 Maturation Time X

IRF (Immature Reticulocyte Fraction): HFR (High Fluorescent Reticulocyte) MFR (Medium Fluorescent Reticulocyte) LFR (Low Fluorescent Reticulocyte) Reference Range: IRF, Female: 1. 1 -15. 9% Male: 1. 5 -13. 7% LFR MFR HFR Low Fluorescence Retics. Medium Fluorescence Retics. High Fluorescence Retics. Little RNA Mature Retics. Reference Interval: 86. 5 -98. 5% More RNA Semi-Mature Retics. Reference Interval: 1. 5 -11. 3% High Level of RNA Immature Retics. Reference Interval: 0 -1. 4%

IRF, a sensitive indicator of erythropoietic activity ■ Serial testing after BMT can show successful engraftment ■ A rise in the IRF occur earlier than any other available test, including absolute neutrophil count ■ IRF >20% from the post BMT value suggests successful erythroid engraftment. ■ IRF is a sensitive measure of early hematopoietic recovery following intensive chemotherapy. ■ An early and reliable indicator of adequacy of response to EPO therapy in patients with anemia of CRF, AIDS and malignancy. ■ It can also be used to monitor response to other treatments for anemia such as iron, folate and vitamin B 12

• Rbc CHr&and %HYPO are direct indicators of FID & ID Retic Parameters • Diagnosis of iron deficiency in early childhood Functional Iron Deficiency (FID) • CHr can provide evidence of a response to iron therapy approx. 4 days after treatment initiation, is to say much ■ The percentage of hypochromic red cellsthat (%HRC) is the bestearlier than variable with other measurements. established forhematological the identification of FID • A- reticulocyte hemoglobin (Ret-He) value <25 pg is Hypochromic red cells are thoseequivalent with Hb <280 g/l. suggestive of classical iron deficiency and also predicts FID in -%HRC≥ 6% was. ESA foundtherapy. to be superior to measurements of s. Tf. R , ZPP, those receiving ferritin & TIBC in differentiating between iron-deficient and iron sufficient • patients. with CRF receiving maintenance doses of ESAs ■ Reticulocyte hemoglobin content (CHr) is the next most established option. CHr <29 pg predicts FID in patients receiving ESA therapy ■ Both tests have limitations in terms of sample stability or equipment availability.

Cytological Assessment of Iron Stores ■ Perls’ Prussian blue reaction or Iron staining of BM, ‘gold standard’ test ■ Assessment can be misleading if insufficient material is available: seven or more particles should be available for review, Few hematologists can honestly say they invariably manage this number on their aspirate films. ■ Inadequate material was a major factor in a study that concluded that > 30% of reports of absence of stainable iron were inaccurate ■ The presence of stainable iron does not define Iron incorporation ■ Furthermore, BM examination is uncomfortable and not without complications, such as post-biopsy pain and bleeding. 2013 John Wiley & Sons Ltd 643 British Journal of Haematology, 2013, 161, 639– 648

Lab. findings, IDA, ACD & IDA+ACD Ferritin <20 μg/L confirms iron deficiency, Sensitivity is poor (59 %– 73%) Ferritin ≤ 30 ng/m. L has a 92% sensitivity and 98% specificity for diagnosing ID in the absence of inflammation [e. g. CRP; < 0. 5 mg/dl] Being a positive acute phase reactant, ferritin levels as high as 100 μg/L can occur in iron deficient patients. S Afr Med J 2016; 106(1): 53 -54. ACD+ID: more frequent in patients with inflammatory diseases and chronic blood losses (e. g. inflammatory bowel disease). Clin Chem Lab Med 2012; 50(8): 1343– 1349

Diagnostic approach to suspected AIHA ■ When a patient presents with suspected AIHA, 3 questions Ashould positive is not specific and is also associated with a be DAT considered. range of non-hemolytic disease states, possibly through 1. wide Is there hemolysis? Typical laboratory findings: passive deposition of IGs –orincreased immune • complexes; examples • Bilirubin (unconjugated) Reticulocyte count - increased include • LDH– may be normal or increased • Haptoglobin – reduced • Liver disease, • Blood film – spherocytes, agglutination or polychromasia • Chronic infection, test Hb-uria • Urinalysis/dipstick • Urinary haemosiderin 1 week after onset intravascular haemolysis • of. Malignancy, • Systemic Lupus Erythematosus (SLE), 2. • Is the hemolysis Renal disorders autoimmune? and A positive DAT such indicates etiology (Ig. G, Ig. A or complement (usually C 3 d) • Drugs as immune intravenous IVIg or Ig. M, antithymocyte globulin. bound to the rbc membrane) 3. What is the type of AIHA? British Journal of Haematology, 2017, 176, 395– 411

■ Positive DAT, Evidence of Hemolysis. Before diagnosing AIHA, ask the following 5 questions: Rarely, AIHA patients test negative with a tube test DAT, for example due to a 1. Is there a history of blood transfusion in the last 3 months? low affinity antibody, a delayed low levels of redtransfusion cell boundreaction antibody or an o Consider hemolytic (DHTR) immunoglobulin not tested for (e. g. organ Ig. A-only AIHA). hematopoietic 2. Has the patient received a solid or allogeneic cell transplant (HSCT)? ■ Astem gel column agglutination method is a more sensitive method that is less prone to oerror thanalloimmune a conventional tubecaused test by major ABO mismatch (HSCT) or Consider hemolysis passenger lymphocyte syndrome (PLS) (solid organ or HSCT). ■ AIHA can be diagnosed in 3% of patients testing negative with a gel card 3. In infants, coulda this be hemolytic disease of the newborn (HDN)? method or by using red cell elution technique 4. Has the patient received any relevant drugs? ■ Recommendation: o Consider drug-induced immune haemolytic anemia (DIIHA). • In patients with unexplained hemolysis and a negative screening DAT, retest there agglutination another known of that hemolysis? with 5. a Is column DATcause method includes monospecific anti-Ig. G, antio Given the high prevalence of an incidental positive DAT within the hospital Ig. A and anti-C 3 d. population, consider whethere is an alternative cause of hemolysis or abnormal laboratory values If also negative, consider preparing and investigating a red cell eluate.

AIHA can be diagnosed in 3% of patients testing negative with a gel card method by using a red cell elution technique Arch Pathol Lab Med—Vol 141, February 2017

DAT Methods Conventional Test Tube (CTT) method - + Am. J. Hematol. 87: 707– 709, 2012. gel micro-Column - + Solid Phase methods - +

Positive DAT in Normal Individuals ■ 0. 1% of healthy blood donors have a positive DAT finding without evidence of hemolysis. ■ A positive DAT can be found in 1, 000– 1: 14, 000 healthy blood donors without hemolysis ■ About 2/3 are positive with Ig. G and 1/3, with complement. ■ The significance of this finding is unclear, but some individuals may go on to develop AIHA or cancer. ■ The DAT is positive in 7– 8% of hospitalized patients and up to 15% of hospitalized patient specimens ■ Therefore, the significance of a DAT requires clinical correlation.

Paroxysmal Cold Hemoglobinuria ■ The rarest type of AIHA, occurs more often in children. ■ The autoantibody is a biphasic hemolysin, which most often has anti-P specificity. ■ The DAT is positive for C 3 d and negative for Ig. G. ■ The diagnosis is confirmed by a Donath-Landsteiner test. ■ A test is positive if hemolysis is detected in the ice followed by incubation at 370 C reaction and not in the melting ice or 370 C reactions. Am. J. Hematol. 87: 707– 709, 2012.

Spherocytosis Hereditary Membrane Defects & Acquired Conditions ■ Hereditary spherocytosis (HS), ■ Hereditary elliptocytosis (HE), • ABO and warm AIHA, • Clostridium perfringens sepsis, • Burns • G 6 PD deficiency AIHA– typical round, dense red cells

METHODS FOR LABORATORY DIAGNOSIS OF HS ■ Screening (+ family history and typical clinical features) - First line: RBC morphology on blood smear, Hematology parameters, Biochemical hemolysis parameters - Second line (reduced area or surface to volume (S/V) ratio, increased osmotic fragility) Hypertonic cryohemolysis, acid glycerol lysis test, osmotic fragility test, pink test Eosine-5 -maleimide binding, EMA ■ Diagnosis ■ SDS-PAGE ■ Ektacytometry with osmotic resistance measurement

CBC / Retic. Parameters in HS ■ MCV is decreased variably in HS with largest decreases noted in severe forms of HS (due to significant decreases in the spectrin content of the rbc memb. ). ■ Importantly, the reticulocyte MCV (MCVr) is also decreased ( to variable extent depending on the severity of anemia). ■ MCVr decrease in HS but not in AIHA or ABO incompatibility (does not decreases) ■ An increased % of hyper-dense cells (Hb conc. >41 g/dl) in association with increased MCHC values of >36 g/dl of mature red cells as well as of reticulocytes (CHCMr). In contrast, CHCMr values are normal in AIHA.

HS with high CHCM >36 g/dl, high % of hyper-dense cells >4%

CBC: Hereditary Spherocytosis

Red cells under microscopic examination in HS β spectrin (SPTB) defect with a lot of acanthocytes (red arrows) in association with spherocytic red cells Band 3 defect with the classical mushroom feature The number of spherocytes is highly variable from patient to patient: very few in 25 to 35% of mild cases of HS and in 33% of HS neonates to very large numbers in the more severe forms of HS.

Confirmatory Tests for HS Used as 1 st line of clinical laboratory tests ■ The Osmotic Fragility Test, OFT (Before & After Incubation) ■ Glycerol Lysis Test ■ Pink test However, the sensitivity of these tests for diagnosis is low ■ 68% for OFT performed on fresh blood, ■ 61% for the glycerol lysis test and ■ 91% for the Pink test. ■ As a result, flow cytometry measurement of the mean red cell fluorescence, associated red cells following labeling with the dye eosin-5′ maleimide (EMA) to document surface area loss is being used an alternate test for diagnosis of HS.

OFT ■ Initiation of Hemolysis RI: 0. 44 % ■ Complete Hemolysis RI: 0. 34 %

Payvand Clinical Specialty Lab. 100% Osmograph MCF(50% lysis), time 0 : 4. 8 (RI: 4. 0 -4. 45) MCF(50% lysis), After 24 Hr. : 6. 2 (RI: 4. 65 -5. 9) 90% 80% % Hemolysis 70% 60% Normal control, time: 0 Normal control, after 24 Hrs 50% Neda Shahkarami, time: 0 Neda Shahkarami, after 24 Hrs 40% 30% 20% 10% 0% 0 1 2 3 4 5 6 Na. Cl conc. (g/L) 7 8 9 10 MCF : Median Corpuscular

Performance of Screening Tests ISLH 2013, May-Jean King

Eosin-5 -Maleimide, EMA Flow Cytometry

Eosin-5′ Maleimide (EMA) Flow Cytometric Test for In HS diagnosis: ■ Sensitivity: 92. 7% & specificity: 99. 1%, ■ Positive Predictive Value, PPV: 97. 8% ; Negative Predictive Value, NPV: 96. 9% ■ The EMA-binding is not dependent on the phenotype and is positive also in compensated HS. ■ independent of the molecular defect in the rbc membrane protein but it may be less sensitive for diagnosis if HS is with undefined molecular defects and with ankyrin defects. ■ The test can also be positive in Pyropoikilocytosis (HPP) ■ Decreased memb. associated fluorescence in patients with congenital dyserythropoietic anemia type II (CDAII)

Advantages of EMA Flow cytometric Test EMA test should replace the much lower sensitive & specific tests since: 1. it is easy to perform particularly in neonates, since only 5 μl of peripheral blood is needed 2. Results are available in 2 to 3 hrs 3. Samples may be analyzed up to 7 days after the blood sampling 4. the gating on the abnormal red cells allows the avoidance of the bias due to presence of transfused red cell enabling the diagnosis of HS in patients with a recent transfusion history.

EMA Report Format

Flow chart for Lab. diagnosis of HS

Diagnostic Tests: SDS-PAGE ■ Determines the extent of membrane deficiency ■ Lack of sensitivity to very mild ‘carrier’ HS Recommended if: - Clinical phenotype more severe than predicted from RBC morphology - RBC morphology is more severe than predicted from parental blood film - Equivocal or borderline results of the screening test - Dx is not clear prior to splenectomy

Challenges in PNH Diagnosis ■ Different/variable clinical presentation ■ The disease is rare & most labs have limited experience in PNH testing ■ Test order is a major problem? ■ Specimen Type; PB or BMA? ■ Routine tests such as Ham's test or sucrose hemolysis test is not sensitive test ■ High Sensitivity Flow Cytometry is the choice method ■ Standardize protocol not followed? !? ! ■ Report format? ■ Proficiency testing?

Common Symptoms of Hemolysis Signs of PNH the Underlying Threat of Catastrophic Consequences Dyspnea Dysphagia Abdominal Pain Impaired Qo. L Fatigue Hemoglobinuria Erectile Dysfunction Anemia DVT Acute Renal Failure Chronic Kidney Disease Stroke / TIA 41 Pulmonary Hypertension Hepatic Failure Cardiac Dysfunction Ischemic Bowel

42

PNH Testing ICCS PNH Guidelines for the diagnosis and monitoring of paroxysmal nocturnal hemoglobinuria and related disorders by flow cytometry. Borowitz MJ, Craig FE, Di. Giuseppe JA, Illingworth AJ, Rosse W, Sutherland DR, Wittwer CT, Richards SJ. Cytometry Part B 2010; 00 B: 000 -000


Patient Testing for PNH Using High Resolution Flow Cytometry at Dahl-Chase Dec 2007 – Nov 15, 2013 ■ Patient Selection based on Diagnostic Pathway - 9, 289 Total screening tests (including follow-up cases) - 8, 836 Total patients screened - 572 PNH positive patients 6. 5% 337 Patients w/ PNH Clones > 1% in WBC 3. 8% 236 Patients w/ minor PNH Clones <1% in WBC 2. 7% ■ Using the Diagnostic Pathway, every 26 th Patient has shown a PNH Clone greater than 1% 45

High-Sensitivity Flow Cytometry Is Needed for Accurate Diagnosis and Monitoring ■ 40% of PNH+ Samples Show a Clone of <1%1 ≤ 1% 46 Clone Size >1% 1. Movalia MK et al. Poster presented at 53 rd Annual meeting of the ASH, San Diego, CA. 2011.

Normal Expression of CD 59 (Type I) and Abnormal Expression of CD 59 (Type II and III) in RBCs Gating on GPA+ (CD 235 a) RBC’s Normal RBC’s with normal CD 59 expression (Type I cells) PNH clone with complete CD 59 deficiency (Type III cells) and partial CD 59 deficiency (Type II cells)

• PNH Leukocyte Assay • Granulocytes and Monocytes: FLAER - CD 24 - CD 14* - CD 15 - CD 45 • Monocytes only (Reflex): FLAER - CD 33** - CD 14 - CD 64** - CD 45

Thank you, any question?
- Slides: 49